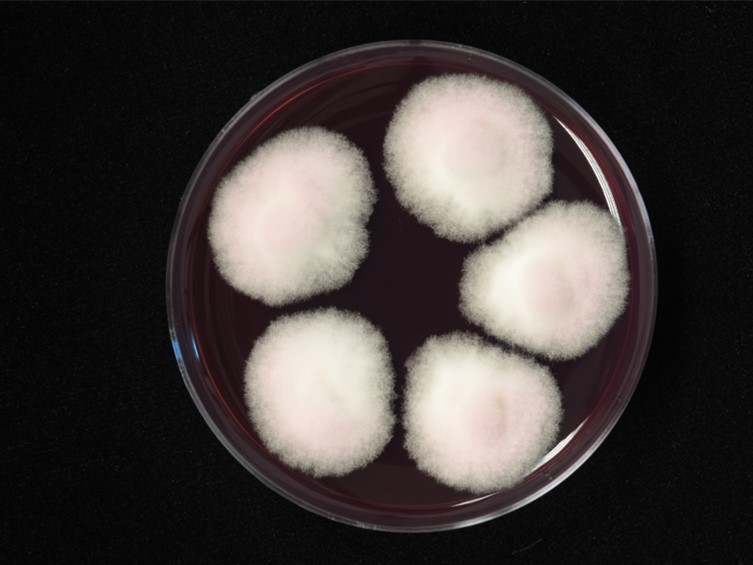

Holotype:
THAILAND, Nakhon Ratchasima Province, Khao Yai National Park, 7 Dec. 1993, N. L. Hywel-Jones, holotype NHJ 2661.
Habitat:
Underside of leaf.
Host:
Adult moths.
Description:
 Synnemata erect, simple, cylindric, several, up to 12 mm high, 50-70 μm diam.
Synnemata erect, simple, cylindric, several, up to 12 mm high, 50-70 μm diam.  Phialides in a monolayer, sparse, on a basal cell, smooth-walled, ellipsoid, 4-8.5 × 2-3.5 μm., terminating in a short but distinct neck, 1.5-3 × 0.5 μm.
Phialides in a monolayer, sparse, on a basal cell, smooth-walled, ellipsoid, 4-8.5 × 2-3.5 μm., terminating in a short but distinct neck, 1.5-3 × 0.5 μm.  Conidia catenate, one- celled, smooth-walled, hyaline, cylindrical, 4-7 × 1-1.5 μm. The synnemata of H. websferi were composed of paralIel strands of hyphae with cells, 4-14 × 1.5-2 μm. The ellipsoid phialides arose from cells perpendicular to the central core. The phialides and their basal cells were sparsely scattered along the synnema with no differentiation into a sterile base and hymenium-like fertile region. There was usually a single phialide on each cell although up to four phialides could arise from a single cell. Conidia were easily detached and did not persist in chains.
Conidia catenate, one- celled, smooth-walled, hyaline, cylindrical, 4-7 × 1-1.5 μm. The synnemata of H. websferi were composed of paralIel strands of hyphae with cells, 4-14 × 1.5-2 μm. The ellipsoid phialides arose from cells perpendicular to the central core. The phialides and their basal cells were sparsely scattered along the synnema with no differentiation into a sterile base and hymenium-like fertile region. There was usually a single phialide on each cell although up to four phialides could arise from a single cell. Conidia were easily detached and did not persist in chains.
Culture characteristics:
Colonies on PDA was slow-growing, 15 mm in 21 d at 21°C, with a white aerial mycelium which produced many short synnemata although there was no evidence of sporulation. Colony reverse was cream-red and a wine-red pigment was in the agar.
Colonies on PDA was slow-growing, 15 mm in 21 d at 21°C, with a white aerial mycelium which produced many short synnemata although there was no evidence of sporulation. Colony reverse was cream-red and a wine-red pigment was in the agar.
Reference:
Hywel-Jones NL (1996). Akanthomyces on spiders in Thailand. Mycological Research 100: 1065–1070.
DOI: https://doi.org/10.1016/S0953-7562(96)80214-0Luangsa-ard JJ, Tasanathai K, Mongkolsamrit S, et al. (2007). Akanthomyces websteri Hywel-Jones. In: Atlas of invertebrate-pathogenic fungi of Thailand Volume 1. National Center for Genetic Engineering and Biotechnology, National Science and Technology Development Agency: 14–15.
Species |
Strain |
Compound |
Pubchem CID |
Biological activity |
Reference |
|---|
|
Strain |
|---|